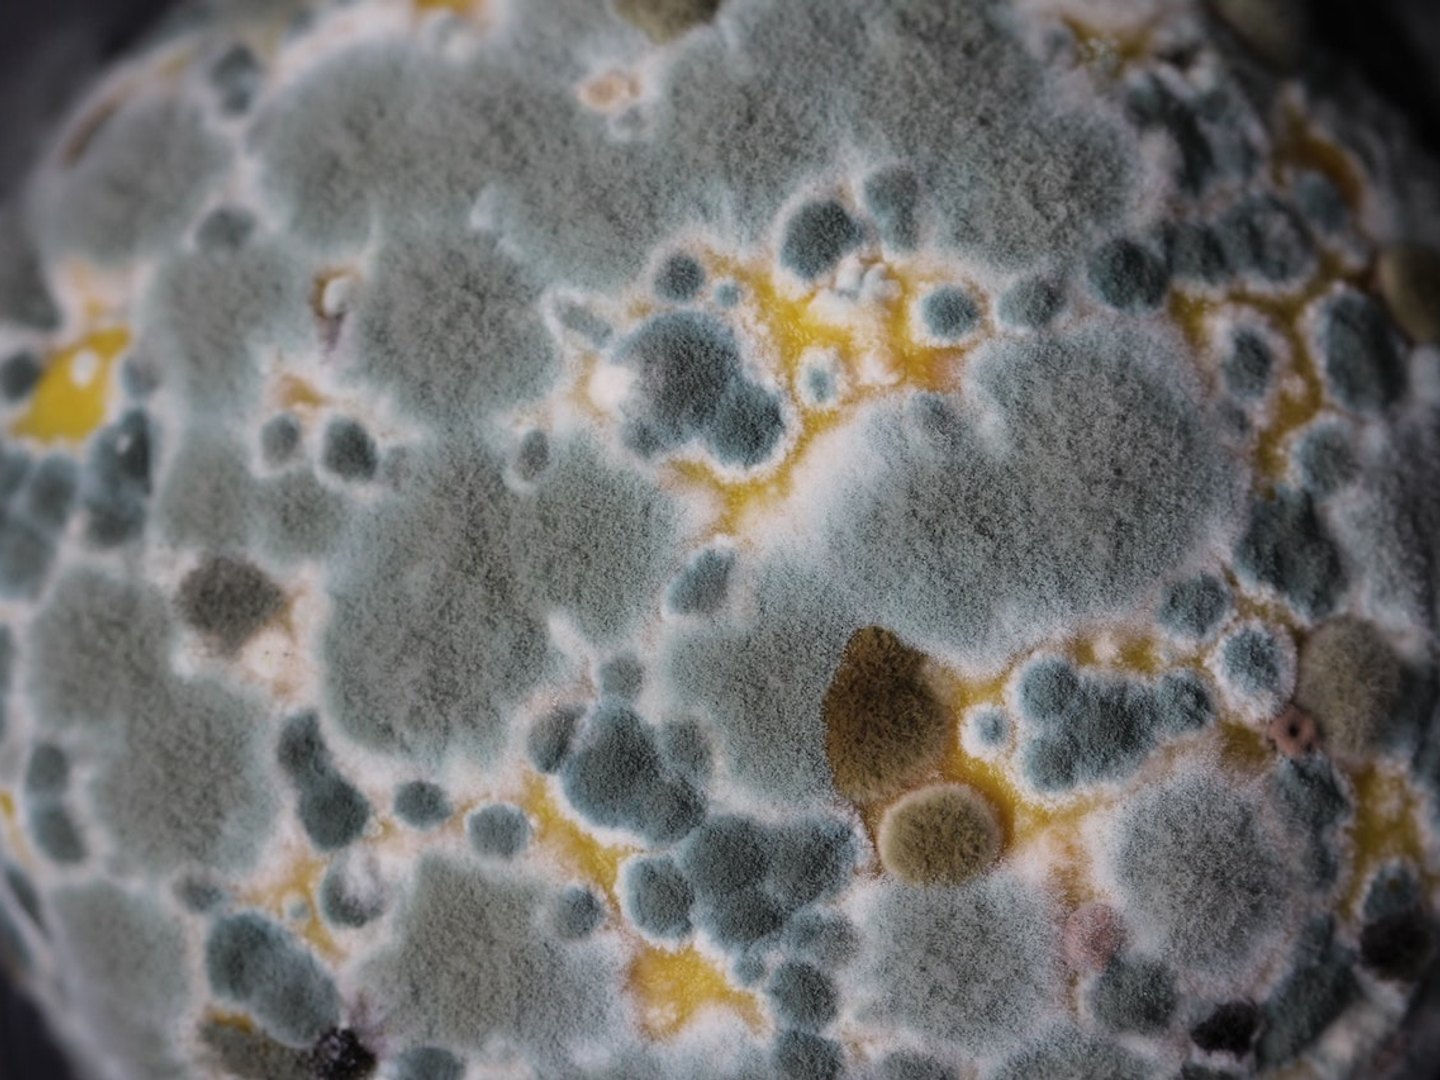

how to test for mold exposure
To do this you will need to. Web Sampling for mold should be conducted by professionals who have specific experience in designing mold sampling protocols sampling methods and.
![]() |
Mold On Carpet The Risks Of Indoor Mold How To Test For It |
Web On this episode of True Health Recovery Doctor Hugh gives a great rundown on mold.
. Web There are several ways to test yourself for mold exposure but each has its own risks and benefits. Web We can test the air quality indoor humidity and any visible mold with moisture meters and surface tape lifts to determine if there are unsafe levels of mold in your building. Web How to Test for Mold Exposure in Body. You can use this single kit in one of three waysto test the air for mold spores to test.
Mold testing will give you a comprehensive mold and. Presence of antibodies such as IgE and IgG can ascertain the possibility of the exposure. Web There are several types of blood tests that your doctor can perform to gauge your exposure to mold. Web How Do Doctors Test For Mold Exposure.
Both of them involve taking a small sample of. You should also avoid an environment that is prone to mold. All the things to know about mold in the body and how it can affect your health. Web The best testing methods to utilize are our urine mycotoxin test and our home environment test the EMMA.
Web There is no blood test for mold. Web If you feel you have been exposed to mold and want to receive a diagnosis you need to undergo medical testing. If you ever experience any of the above-mentioned symptoms immediately see a doctor. Web Heres how to tell if youre dealing with a mold problem or just a bit of grime.
Testing yourself for mold exposure is usually the best way to. Put a Q-tip in some diluted bleach and dab it on the area in question. Web In order to do a self-test you will want to make sure you dont have any allergies to mold. Web A blood test can detect the possibility of the exposure to this fungi.
Measure from the moldy area to a reference point like a. Web There are two different kinds of professional-grade tests that experts tend to utilize to look for mold infestations. Several tests are recommended. Some include the MELISA test which is used to detect allergies to molds.
Prepare the Room Before performing the mold test close the doors windows and vents in the room that you plan to test for a full 24 hours. Some physicians can do allergy testing for possible allergies to mold but no clinically proven tests can pinpoint when or where a particular. If you are worried about mold exposure in your. Web How to Test for Mold 1.
Web If mold is growing on an exterior wall or ceiling first look for a leak in the wall or roof as a test for mold. Mold exposure can cause a variety of health problems ranging from minor irritations to serious respiratory illnesses. Web The Mold Armor kit includes a test swab petri dish and a bottle of mold growth medium.
![]() |
Mold 101 Mold Toxicity Dr Neil Paulvin |
![]() |
Mold Toxicity Black Mold Symptoms Solutions Microbe Formulas |
![]() |
How To Test For Black Mold This Old House |
![]() |
Mold A Catalyst For Illness Dr Jaban |
![]() |
Our Mold Exposure Test Medical Mold Toxins Test Biocide Labs |
Posting Komentar untuk "how to test for mold exposure"